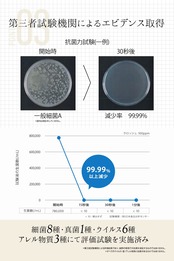

・翌月にまとめてお支払い可能
・手数料無料(口座振替の場合)
・アプリでご利用金額を確認できて安心

¥16,643 税込
なら 手数料無料の 翌月払いでOK
この商品は送料無料です。
CHLOsh (クロッシュ) 詰替(5L) 200ppm 除菌消臭 (安定型次亜塩素酸ナトリウム) 大容量 バッグインボックス(無香料)
◆プロの現場でも活躍する タップリ使えるバッグイン入りです。 (5L,10L,20Lは充填用S字コック付属)
お手持ちのプッシュ式又はトリガー式のクロッシュに詰め替えてご使用ください。
そのまま冷暗所(室内の直射日光が当たらない場所)に保管いただければ、イザという時の防災備蓄用としてお役立ていただけます。
ブランド CHLOSH(クロッシュ)
商品の形状 液体
商品用途・使用方法 トイレ
商品体積 5 リットル
ユニット数 1.00 個
表示を増やす
送料・配送方法について
お支払い方法について